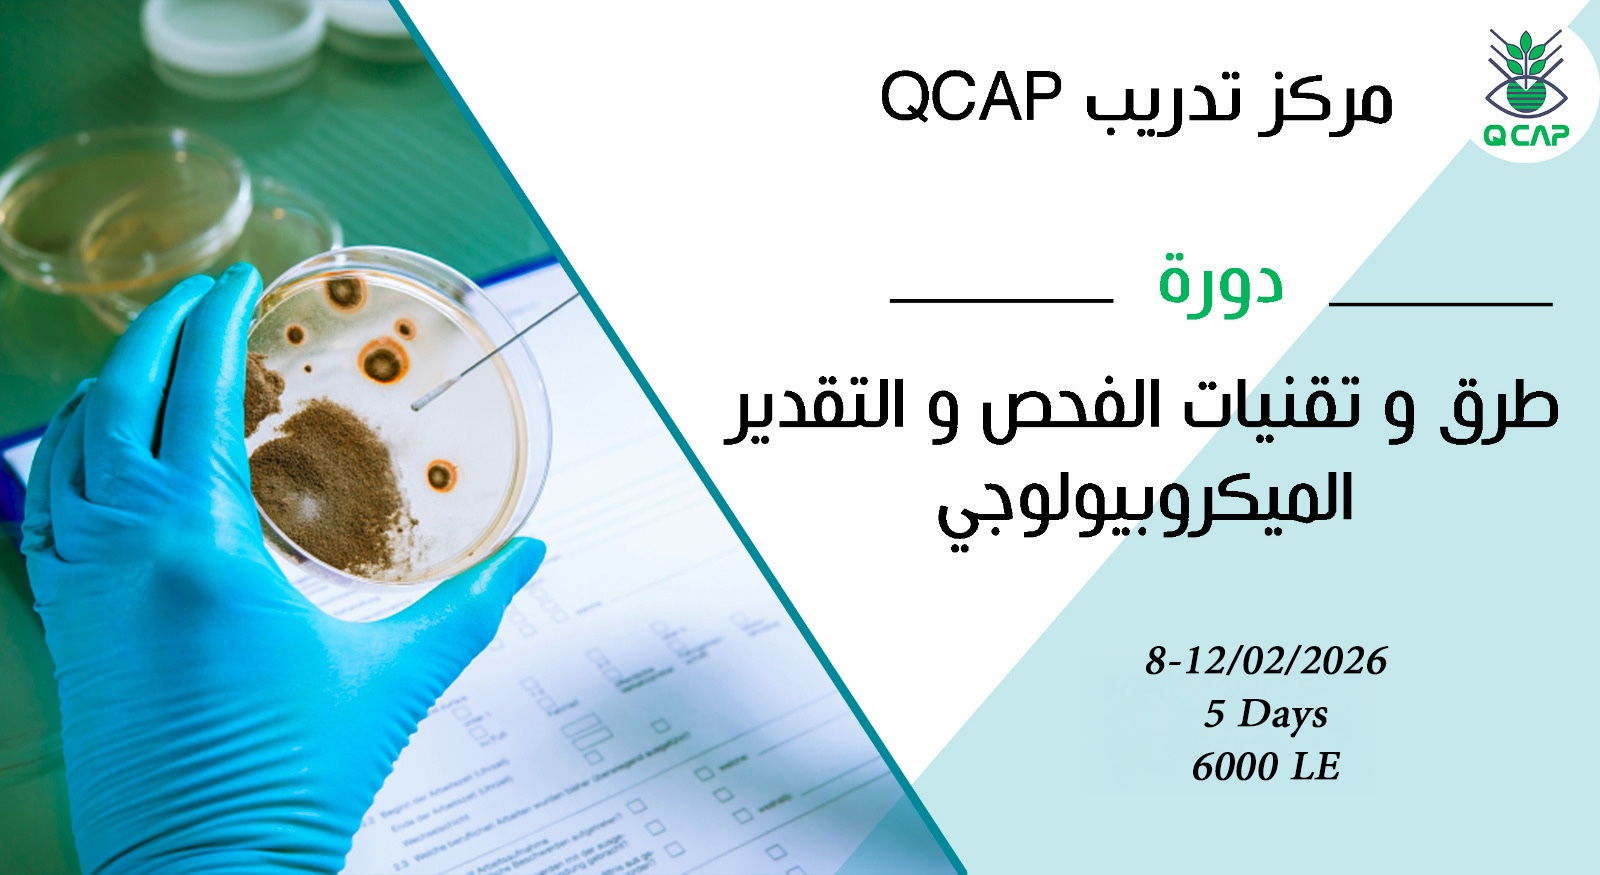

محتوى البرنامج
نعلن عن بدء التسجيل للدورة التدريبية
” طرق و تقنيات الفحص والتقدير الميكروبيولوجى”
يعلن مركز تدريب QCAP التابع للمعمل المركزي لتحليل متبقيات المبيدات والعناصر الثقيلة في الأغذية QCAP
عن الدورة التدريبية :
“طرق وتقنيات الفحص والتقدير الميكروبي فى العينات الغذائية والبيئية”
(Microbiological Detection and Enumeration Techniques in Food and Environmental Samples)
مكان البرنامج التدريبي:
المعمل المركزي لتحليل متبقيات المبيدات والعناصر الثقيلة في الأغذية- مركز تدريب QCAP- 7 ش نادي الصيد – الدقي- الجيزة.
تاريخ البرنامج التدريبي
08-12 فبراير 2026
مدة البرنامج التدريبي:
5 أيام
البرنامج التدريبي :
محتوى مقدمة عن مسببات الأمراض الغذائية.
تقنيات و طرق الكشف عن مسببات الأمراض الميكروبية.
الطرق القياسية لإعداد العينات بهدف تقدير مسببات الأمراض الميكروبية فى العينات الغذائية والبيئية.
طرق التعقيم وإعداد ميديات التغذية.
طرق العد البكتيري الكلي.
الطرق الميكروبيولوجية لفحص السالمونيلا.
الطرق الميكروبيولوجية لفحص الليستريا.
الطرق الميكروبيولوجية لفحص بكتريا كلوستريديوم.
الطرق الميكروبيولوجية لفحص المكورات المعوية.
الطرق الميكروبيولوجية لفحص المكورات العنقودية الذهبية.
الطرق الميكروبيولوجية لفحص الشيجلا.
الطرق الميكروبيولوجية لفحص القولونيات.
الطرق الميكروبيولوجية لفحص البكتريا الأمعائية.
الطرق الميكروبيولوجية لفحص الإشريكية القولونية.
طرق فحص الخمائر.
تقنيات ال PCR للفحص الميكروبي وتعريف السلالات البكتيرية Sero-typing .
تنظيم وإدارة مراقبة الجودة وفقا لمواصفة ايزو القياسية 17025.
اجراءات مراقبة الجودة الداخلية (IQC) للإجراءات وطرق التحليل الميكروبية.
تحصل في أول يوم للبرنامج التدريبي على نسخة الكترونية للمحاضرات+ بلوك نوت+ قلم
في نهاية البرنامج تحصل على شهادة معتمدة من مركز التدريب QCAP بشرط حضور عدد الساعات المحددة.
تستفيد بعد حصولك على هذا البرنامج بأن تكون أحد أعضاء مركز تدريب QCAP وتحظى طوال الوقت بحصولك على الاستشارات الفنية مجاناً.
تكاليف البرنامج التدريبي:
تكلفة الفرد الواحد 6000 جنيه ( ستة الأف جنيه مصري) شاملة وجبة غذاء مع المشروبات
ويوجد أسعار مخفضة للمجموعات من الشركات كما يوجد نسب خصم للشركات أعضاء المجالس التصديري للحاصلات الزراعية وغرفة الصناعات الغذائية والمجلس التصديري للصناعات الغذائية، وخصومات خاصة لطلاب الجامعات والخريجين الجدد بأسعار مخفضة.
نبذة عن المدربين بالمركز:
يضم مركز تدريب QCAP نخبة من أفضل المدربين في جميع التخصصات المختلفة في مصر والوطن العربي ومنطقة الشرق الأوسط ويأتي ذلك من خلال تراكم الخبرات العملية طوال أكثر من 27 عام بمعمل QCAP- المدربين أساتذة بمركز البحوث الزراعية حاصلين على درجات علمية رفيعة (الماجستير والدكتوراه ) ويعملون لدى جهات الإعتماد الدولية كخبراء في مجال عملهم
سارع بالتسجيل نظراً لأن العدد محدود
أو على الإيميل:
training@qcap-egypt.com
أو كلمنا على التليفون الأرضي: 0237499718
للإطلاع على كافة خدمات المعمل تابعونا على : www.qcap-egypt.com
أو على الصفحة الرسمية للمعمل: https://www.facebook.com/QCAPLab
او على اللينكدين: linkedin.com/in/qcap-المعمل-المركزى-لتحليل-متبقيات-المبيدات-a69b5b14a
أو على توتير: https://twitter.com/EgyQcap
سارع بالتسجيل نظراً لأن العدد محدود